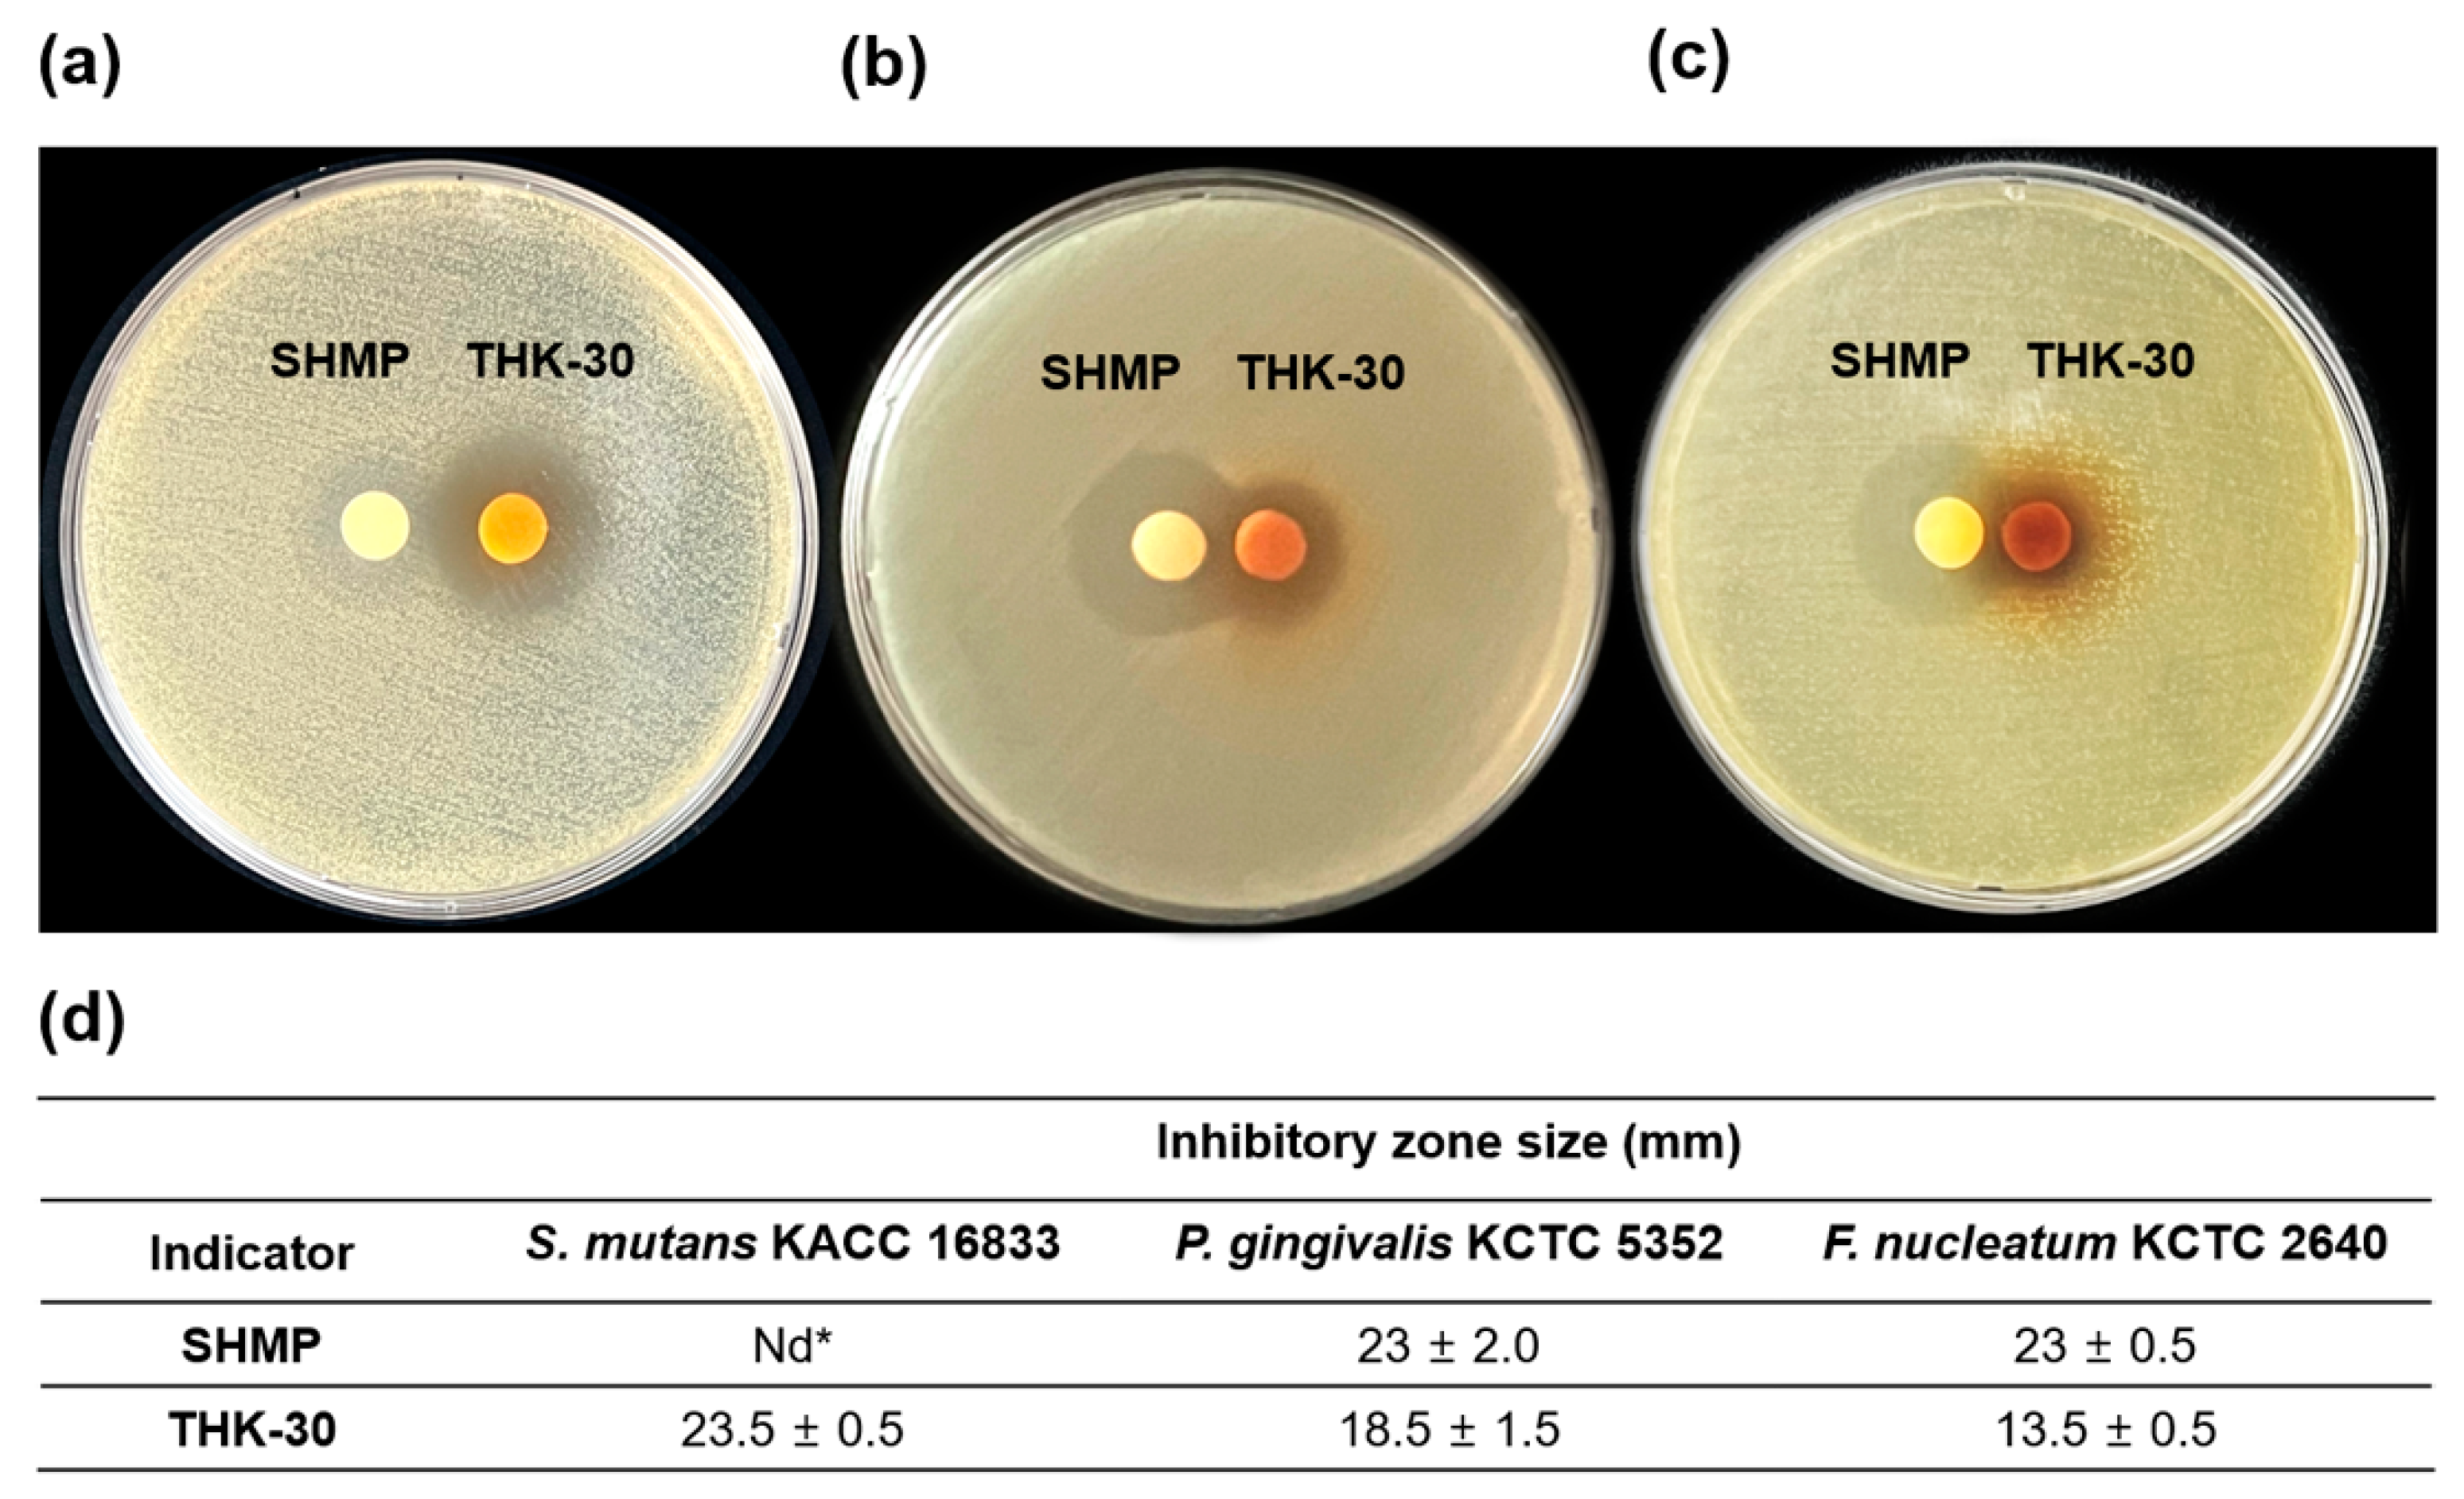
Jfb 15 00064 g006

The Potential Teeth Bleaching and Halitosis Prevention Effects of Pediococcus inopinatus THK-30, a Kimchi-Derived Lactic Acid Bacterium: In Vitro Study
Abstract
:1. Introduction
2. Materials and Methods
2.1. Bacteria Isolation, Identification, and Cultivation
2.2. Bacterial Growth Conditions and Metabolite Preparation
2.3. Teeth Bleaching Test Preparation
2.3.1. Artificial Teeth Staining
2.3.2. Teeth Bleaching Assay
2.4. Broth Microdilution Method
2.5. Biofilm Formation Crystal Violet Assay
2.6. SHMP and THK-30 Synergy Test
2.7. Teeth Biofilm Assay
2.8. Enzymatic Characterization of Sample CFS
2.9. Statistical Analysis
3. Results
3.1. Isolation of Antibacterial LAB
3.2. Identification of Strain THK-30
3.3. P. inopinatus THK-30 Effect on Teeth Bleaching with and without SHMP
3.4. P. inopinatus THK-30 Synergy Effect in Antibacterial with SHMP
3.5. P. inopinatus THK-30 Interferes with the Biofilm Formation of Oral Pathogen Bacteria
3.6. P. inopinatus THK-30 Interferes with the Artificial Teeth Biofilm Forming
3.7. P. inopinatus THK-30 Active Substance Analysis Using Enzyme-Treating Assay
4. Discussion
5. Conclusions
Author Contributions
Funding
Data Availability Statement
Acknowledgments
Conflicts of Interest
References
- Fiorillo, L. Oral Health: The First Step to Well-Being. Medicina 2019, 55, 676. [Google Scholar] [CrossRef] [PubMed]
- Ocak, Y.; Cicek, O.; Ozkalayci, N.; Erener, H. Investigation of the Relationship between Sagittal Skeletal Nasal Profile Morphology and Malocclusions: A Lateral Cephalometric Film Study. Diagnostics 2023, 13, 463. [Google Scholar] [CrossRef] [PubMed]
- Li, Z.; Li, J.; Fu, R.; Liu, J.; Wen, X.; Zhang, L. Halitosis: Etiology, Prevention, and the Role of Microbiota. Clin. Oral Investig. 2023, 27, 6383–6393. [Google Scholar] [CrossRef]
- Kothari, S.; Gray, A.R.; Lyons, K.; Tan, X.W.; Brunton, P.A. Vital Bleaching and Oral-Health-Related Quality of Life in Adults: A Systematic Review and Meta-Analysis. J. Dent. 2019, 84, 22–29. [Google Scholar] [CrossRef] [PubMed]
- Kahler, B. Present Status and Future Directions—Managing Discoloured Teeth. Int. Endod. J. 2022, 55, 922–950. [Google Scholar] [CrossRef]
- Kim, S.; Chung, S.H.; Kim, R.J.Y.; Park, Y.-S. Investigating the Role of Chlorogenic Acids and Coffee Type in Coffee-Induced Teeth Discoloration. Acta Odontol. Scand. 2024, 82, 1–8. [Google Scholar] [CrossRef]
- Wang, Y.; Ryu, R.; Seo, J.-M.; Lee, J.-J. Effects of Conventional and Heated Tobacco Product Smoking on Discoloration of Artificial Denture Teeth. J. Prosthet. Dent. 2022, 128, 206–210. [Google Scholar] [CrossRef] [PubMed]
- Frank, A.C.; Kanzow, P.; Rödig, T.; Wiegand, A. Comparison of the Bleaching Efficacy of Different Agents Used for Internal Bleaching: A Systematic Review and Meta-Analysis. J. Endod. 2022, 48, 171–178. [Google Scholar] [CrossRef]
- Memon, M.A.; Memon, H.A.; Muhammad, F.E.; Fahad, S.; Siddiqui, A.; Lee, K.Y.; Tahir, M.J.; Yousaf, Z. Aetiology and Associations of Halitosis: A Systematic Review. Oral Dis. 2023, 29, 1432–1438. [Google Scholar] [CrossRef]
- Briceag, R.; Caraiane, A.; Raftu, G.; Horhat, R.M.; Bogdan, I.; Fericean, R.M.; Shaaban, L.; Popa, M.; Bumbu, B.A.; Bratu, M.L.; et al. Emotional and Social Impact of Halitosis on Adolescents and Young Adults: A Systematic Review. Medicina 2023, 59, 564. [Google Scholar] [CrossRef]
- Li, C.; Wu, Y.; Xie, Y.; Zhang, Y.; Jiang, S.; Wang, J.; Luo, X.; Chen, Q. Oral Manifestations Serve as Potential Signs of Ulcerative Colitis: A Review. Front. Immunol. 2022, 13, 1013900. [Google Scholar] [CrossRef] [PubMed]
- Hampelska, K.; Jaworska, M.M.; Babalska, Z.Ł.; Karpiński, T.M. The Role of Oral Microbiota in Intra-Oral Halitosis. J. Clin. Med. 2020, 9, 2484. [Google Scholar] [CrossRef] [PubMed]
- Jakubovics, N.S.; Goodman, S.D.; Mashburn-Warren, L.; Stafford, G.P.; Cieplik, F. The Dental Plaque Biofilm Matrix. Periodontol. 2000 2021, 86, 32–56. [Google Scholar] [CrossRef] [PubMed]
- Sangha, J.S.; Barrett, P.; Curtis, T.P.; Métris, A.; Jakubovics, N.S.; Ofiteru, I.D. Effects of Glucose and Lactate on Streptococcus mutans Abundance in a Novel Multispecies Oral Biofilm Model. Microbiol. Spectr. 2024. ahead of print. [Google Scholar] [CrossRef]
- Ikawa, T.; Mizutani, K.; Sudo, T.; Kano, C.; Ikeda, Y.; Akizuki, T.; Kobayashi, H.; Izumi, Y.; Iwata, T. Clinical Comparison of an Electric-powered Ionic Toothbrush and a Manual Toothbrush in Plaque Reduction: A Randomized Clinical Trial. Int. J. Dent. Hyg. 2021, 19, 93–98. [Google Scholar] [CrossRef] [PubMed]
- Vitiello, F.; Monterubbianesi, R.; Sparabombe, S.; Bourgeois, D.; Tosco, V.; Alshehri, F.A.; Carrouel, F.; Putignano, A.; Orsini, G. Use of Over-the-Counter Mouthwashes as an Additional Measure in Individual Oral Prophylaxis on Adults with Plaque-Induced Gingivitis: A Double-Blind, Parallel, Randomized Controlled Trial. BMC Oral Health 2024, 24, 83. [Google Scholar] [CrossRef]
- Cha, J.; Kim, Y.B.; Park, S.-E.; Lee, S.H.; Roh, S.W.; Son, H.-S.; Whon, T.W. Does Kimchi Deserve the Status of a Probiotic Food? Crit. Rev. Food Sci. Nutr. 2023, 1–14. [Google Scholar] [CrossRef]
- Park, D.-W.; Lee, H.S.; Shim, M.-S.; Yum, K.J.; Seo, J.T. Do Kimchi and Cheonggukjang Probiotics as a Functional Food Improve Androgenetic Alopecia? A Clinical Pilot Study. World J. Men’s Health 2020, 38, 95. [Google Scholar] [CrossRef]
- An, J.M.; Kang, E.A.; Han, Y.-M.; Oh, J.Y.; Lee, D.Y.; Choi, S.H.; Kim, D.H.; Hahm, K.B. Dietary Intake of Probiotic Kimchi Ameliorated IL-6-Driven Cancer Cachexia. J. Clin. Biochem. Nutr. 2019, 65, 109–117. [Google Scholar] [CrossRef]
- Hyun, I.-K.; Hong, S.W.; Ma, M.-J.; Chang, J.Y.; Lee, S.; Yun, Y.-R. Anti-Obesity Effect of Kimchi with Starter Cultures in 3T3-L1 Cells. J. Microbiol. Biotechnol. 2024, 34, 123–131. [Google Scholar] [CrossRef]
- Lu, R.; Shang, M.; Zhang, Y.-G.; Jiao, Y.; Xia, Y.; Garrett, S.; Bakke, D.; Bäuerl, C.; Martinez, G.P.; Kim, C.-H.; et al. Lactic Acid Bacteria Isolated From Korean Kimchi Activate the Vitamin D Receptor–Autophagy Signaling Pathways. Inflamm. Bowel Dis. 2020, 26, 1199–1211. [Google Scholar] [CrossRef]
- Mun, S.Y.; Lee, W.; Lee, S.-Y.; Chang, J.Y.; Chang, H.C. Pediococcus inopinatus with a Well-Developed CRISPR-Cas System Dominates in Long-Term Fermented Kimchi, Mukeunji. Food Microbiol. 2024, 117, 104385. [Google Scholar] [CrossRef]
- Chae, S.W.; Shim, G.S.; Hong, S.W.; No, S.W.; Hwang, H.R.; Lee, H.J. Composition for Relieving Hangover Containing Pediococcus Inopinatus as Active Ingredient. Korea Patent WO2021125822A1, 24 June 2021. [Google Scholar]
- Kang, M.-S.; Lee, Y.-G.; Kim, H.-S.; Chung, H.-S.; Hwang, D.-Y.; Kim, D.-S. Therapeutic Antiallergy Effect of Fermented Soy Curd by Pediococcus inopinatus Y2. J. Life Sci. 2019, 29, 478–483. [Google Scholar] [CrossRef]
- Yi, E.-J.; Kim, A.-J. Antimicrobial and Antibiofilm Effect of Bacteriocin-Producing Pediococcus inopinatus K35 Isolated from Kimchi against Multidrug-Resistant Pseudomonas aeruginosa. Antibiotics 2023, 12, 676. [Google Scholar] [CrossRef]
- Sulieman, M.; Addy, M.; Macdonald, E.; Rees, J.S. A Safety Study In Vitro for the Effects of an In-Office Bleaching System on the Integrity of Enamel and Dentine. J. Dent. 2004, 32, 581–590. [Google Scholar] [CrossRef] [PubMed]
- Acuña, E.D.; Parreiras, S.O.; Favoreto, M.W.; Cruz, G.P.; Gomes, A.; Borges, C.P.F.; Loguercio, A.D.; Reis, A. In-office Bleaching with a Commercial 40% Hydrogen Peroxide Gel Modified to Have Different pHs: Color Change, Surface Morphology, and Penetration of Hydrogen Peroxide into the Pulp Chamber. J. Esthet. Restor. Dent. 2022, 34, 322–327. [Google Scholar] [CrossRef]
- Marjanovic, J.; Veljovic, D.N.; Stasic, J.N.; Savic-Stankovic, T.; Trifkovic, B.; Miletic, V. Optical Properties of Composite Restorations Influenced by Dissimilar Dentin Restoratives. Dent. Mater. 2018, 34, 737–745. [Google Scholar] [CrossRef] [PubMed]
- Pecho, O.E.; Ghinea, R.; Alessandretti, R.; Pérez, M.M.; Della Bona, A. Visual and Instrumental Shade Matching Using CIELAB and CIEDE2000 Color Difference Formulas. Dent. Mater. 2016, 32, 82–92. [Google Scholar] [CrossRef] [PubMed]
- Ozdemir, Z.M.; Surmelioglu, D. Effects of Different Bleaching Application Durations on Enamel in Terms of Tooth Color, Microhardness, and Surface Roughness. Color Res. Appl. 2022, 47, 204–212. [Google Scholar] [CrossRef]
- Humphries, R.; Bobenchik, A.M.; Hindler, J.A.; Schuetz, A.N. Overview of Changes to the Clinical and Laboratory Standards Institute Performance Standards for Antimicrobial Susceptibility Testing, M100, 31st Edition. J. Clin. Microbiol. 2021, 59, e00213-21. [Google Scholar] [CrossRef] [PubMed]
- Laishram, S.; Pragasam, A.K.; Bakthavatchalam, Y.D.; Veeraraghavan, B. An Update on Technical, Interpretative and Clinical Relevance of Antimicrobial Synergy Testing Methodologies. Indian J. Med. Microbiol. 2017, 35, 445–468. [Google Scholar] [CrossRef]
- Eshed, M.; Lellouche, J.; Matalon, S.; Gedanken, A.; Banin, E. Sonochemical Coatings of ZnO and CuO Nanoparticles Inhibit Streptococcus mutans Biofilm Formation on Teeth Model. Langmuir 2012, 28, 12288–12295. [Google Scholar] [CrossRef] [PubMed]
- Lim, H.-S.; Yeu, J.-E.; Hong, S.-P.; Kang, M.-S. Characterization of Antibacterial Cell-Free Supernatant from Oral Care Probiotic Weissella cibaria, CMU. Molecules 2018, 23, 1984. [Google Scholar] [CrossRef] [PubMed]
- Neves, J.G.; Danelon, M.; Pessan, J.P.; Figueiredo, L.R.; Camargo, E.R.; Delbem, A.C.B. Surface Free Energy of Enamel Treated with Sodium Hexametaphosphate, Calcium and Phosphate. Arch. Oral Biol. 2018, 90, 108–112. [Google Scholar] [CrossRef]
- Pietrangelo, L.; Magnifico, I.; Petronio, G.P.; Cutuli, M.A.; Venditti, N.; Nicolosi, D.; Perna, A.; Guerra, G.; Marco, R. A Potential “Vitaminic Strategy” against Caries and Halitosis. Appl. Sci. 2022, 12, 2457. [Google Scholar] [CrossRef]
- Ihalin, R.; Nuutila, J.; Loimaranta, V.; Lenander, M.; Tenovuo, J.; Lilius, E.-M. Susceptibility of Fusobacterium nucleatum to Killing by Peroxidase–Iodide–Hydrogen Peroxide Combination in Buffer Solution and in Human Whole Saliva. Anaerobe 2003, 9, 23–30. [Google Scholar] [CrossRef] [PubMed]
- Lawrence, G.W.; McCarthy, N.; Walsh, C.J.; Kunyoshi, T.M.; Lawton, E.M.; O’Connor, P.M.; Begley, M.; Cotter, P.D.; Guinane, C.M. Effect of a Bacteriocin-Producing Streptococcus salivarius on the Pathogen Fusobacterium nucleatum in a Model of the Human Distal Colon. Gut Microbes 2022, 14, 2100203. [Google Scholar] [CrossRef] [PubMed]
- Kniel, K.E.; Sumner, S.S.; Pierson, M.D.; Zajac, A.M.; Hackney, C.R.; Fayer, R.; Lindsay, D.S. Effect of Hydrogen Peroxide and Other Protease Inhibitors on Cryptosporidium parvum Excystation and In Vitro Development. J. Parasitol. 2004, 90, 885–888. [Google Scholar] [CrossRef] [PubMed]
- Huang, N.; Li, J.; Qiao, X.; Wu, Y.; Liu, Y.; Wu, C.; Li, L. Efficacy of Probiotics in the Management of Halitosis: A Systematic Review and Meta-Analysis. BMJ Open 2022, 12, e060753. [Google Scholar] [CrossRef]
- Kumar, A.; Qanungo, K. Advanced Materials for Prevention of Calculus Formation on Enamel: A Review. AIP Conf. Proc. 2023, 2779, 020005. [Google Scholar] [CrossRef]
- Hojo, K.; Nagaoka, S.; Ohshima, T.; Maeda, N. Bacterial Interactions in Dental Biofilm Development. J. Dent. Res. 2009, 88, 982–990. [Google Scholar] [CrossRef] [PubMed]
- Dodds, M.; Roland, S.; Edgar, M.; Thornhill, M. Saliva A Review of Its Role in Maintaining Oral Health and Preventing Dental Disease. BDJ Team 2015, 2, 15123. [Google Scholar] [CrossRef]
- Buzalaf, M.A.R.; Hannas, A.R.; Kato, M.T. Saliva and Dental Erosion. J. Appl. Oral Sci. 2012, 20, 493–502. [Google Scholar] [CrossRef]
- Helm, J.F.; Dodds, W.J.; Hogan, W.J.; Soergel, K.H.; Egide, M.S.; Wood, C.M. Acid Neutralizing Capacity of Human Saliva. Gastroenterology 1982, 83, 69–74. [Google Scholar] [CrossRef] [PubMed]
- Abikshyeet, P.; Mishra, P.; Bhuyan, L.; Kumar, V.; Mahapatra, N.; Adhikary, T. Probiotics: Dawn of a New Era in Dental Caries Management. J. Pharm. Bioallied Sci. 2022, 14, S34–S38. [Google Scholar] [CrossRef] [PubMed]
- Rajabi, Z.; Soltan Dallal, M.M.; Afradi, M.R.; Erfani, Y.; Alinejad, D.; Ranjbar, R.; Kasra-Kermanshahi, R. Comparison of the Effect of Extracted Bacteriocin and Lytic Bacteriophage on the Expression of Biofilm Associated Genes in Streptococcus mutans. Adv. Mater. Sci. Eng. 2022, 2022, 5035280. [Google Scholar] [CrossRef]
- Butera, A.; Gallo, S.; Maiorani, C.; Molino, D.; Chiesa, A.; Preda, C.; Esposito, F.; Scribante, A. Probiotic Alternative to Chlorhexidine in Periodontal Therapy: Evaluation of Clinical and Microbiological Parameters. Microorganisms 2020, 9, 69. [Google Scholar] [CrossRef]
- Myers, M.L.; Browning, W.D.; Downey, M.C.; Hackman, S.T. Clinical Evaluation of a 3% Hydrogen Peroxide Tooth-Whitening Gel. J. Esthet. Restor. Dent. 2003, 15, 50–56. [Google Scholar] [CrossRef]
- Cornacchione, L.P.; Hu, L.T. Hydrogen Peroxide-Producing Pyruvate Oxidase from Lactobacillus Delbrueckii Is Catalytically Activated by Phosphotidylethanolamine. BMC Microbiol. 2020, 20, 128. [Google Scholar] [CrossRef]
- Kawamoto, K.; Tsujimoto, Y. Effects of the Hydroxyl Radical and Hydrogen Peroxide on Tooth Bleaching. J. Endod. 2004, 30, 45–50. [Google Scholar] [CrossRef]
- Nithyashri, P. Mode of Failure Analysis of Composite Resin to Bleached Enamel Pretreated with Probiotics—An In Vitro Study. Int. J. Endod. Rehabil. 2023, 1, 16–21. [Google Scholar]
- Nathanson, D. Vital tooth bleaching: Sensitivity and pulpal considerations. J. Am. Dent. Assoc. 1997, 128, 41S–44S. [Google Scholar] [CrossRef] [PubMed]
- Demarco, F. Erosion and Abrasion on Dental Structures Undergoing At-Home Bleaching. Clin. Cosmet. Investig. Dent. 2011, 3, 45–52. [Google Scholar] [CrossRef] [PubMed]
- Yousefi, N.; Abbasi, S.; Azarikia, F.; Azizi, M.-H. Solubilization of Concentrated Protein Dispersion: Effect of Hydrogen Peroxide (H2O2) and Sodium Hexametaphosphate (SHMP). Food Chem. 2023, 400, 133980. [Google Scholar] [CrossRef]

| Strain | MIC (mg/mL) | MBC (mg/mL) |
|---|---|---|
| Gram-positive bacteria | ||
| Streptococcus mutans KACC 16833 | ≥5 | 10 |
| Streptococcus gordonii KACC 13829 | ≥2.5 | 5 |
| Streptococcus mitis KACC 16832 | ≥2.5 | 5 |
| Streptococcus downei KACC 13827 | ≥5 | nd 1 |
| Streptococcus ferus KACC 13881 | ≥1.25 | 2.5 |
| Gram-negative bacteria | ||
| Porphyromonas gingivalis KCTC 5352 | 40 | nd |
| Fusobacterium nucleatum KCTC 2640 | 40 | nd |
| THK-30 | DSM 20285T | |
|---|---|---|
| Isolation Source: | Kimchi | Brewery Yeast |
| Growth Temperature: | ||
| 25 °C | + 1 | + |
| 30 °C | + | + |
| 37 °C | w 2 | w |
| 45 °C | w | w |
| Acid produced from: | ||
| D-galactose | + | + |
| D-glucose | + | + |
| D-fructose | + | + |
| D-mannose | + | + |
| Methyl-α-D-mannopyranoside | − 3 | − |
| N-acetylglucosamine | + | + |
| Amygdalin | + | + |
| Esculin ferric citrate | + | + |
| Salicin | + | + |
| D-cellobiose | + | + |
| D-maltose | w | w |
| D-trehalose | + | + |
| Gentiobiose | + | + |
| D-turanose | − | − |
| Treatment Time (Week) | Group | In-Office Bleaching | Brushing and Mouthwash | ||||||||||
|---|---|---|---|---|---|---|---|---|---|---|---|---|---|
| ΔL | Δa | Δb | ΔL | Δa | Δb | ||||||||
| Mean | SD | Mean | SD | Mean | SD | Mean | SD | Mean | SD | Mean | SD | ||
| 1 | Blank | −1.233 | 0.513 | 0.100 | 0.000 | 1.367 | 0.306 | −1.667 | 0.208 | −0.633 | 1.877 | −2.133 | 0.850 |
| Control | −0.033 | 0.404 | −2.067 | 0.416 | −5.967 | 2.003 | 0.667 | 0.208 | −2.700 | 0.100 | −7.067 | 1.858 | |
| THK−30 | 3.033 | 0.153 | −2.867 | 0.379 | −7.733 | 1.940 | 0.967 | 0.153 | −2.733 | 0.115 | −6.933 | 2.013 | |
| SHMP | 3.400 | 0.721 | −3.500 | 0.100 | −7.967 | 1.620 | 3.367 | 0.058 | −2.433 | 0.153 | −7.433 | 1.943 | |
| Mix | 3.933 | 0.586 | −3.367 | 0.058 | −9.567 | 1.893 | 4.300 | 0.000 | −2.833 | 0.208 | −9.700 | 1.992 | |
| 2 | Blank | −2.333 | 0.153 | 0.133 | 1.531 | −3.767 | 0.462 | −2.600 | 0.265 | −0.400 | 0.100 | −3.333 | 0.231 |
| Control | 0.000 | 0.436 | −2.400 | 0.100 | −7.133 | 1.358 | 2.100 | 0.100 | −2.267 | 0.058 | −7.067 | 1.629 | |
| THK−30 | 3.233 | 0.058 | −3.467 | 0.252 | −7.267 | 1.332 | 2.967 | 0.115 | −3.067 | 0.115 | −7.400 | 1.778 | |
| SHMP | 3.933 | 0.115 | −2.900 | 0.361 | −8.833 | 0.907 | 4.100 | 0.300 | −2.767 | 0.058 | −8.700 | 1.400 | |
| Mix | 4.267 | 0.153 | −3.200 | 0.265 | −9.000 | 0.800 | 4.333 | 0.153 | −2.700 | 0.200 | −6.333 | 1.290 | |
| 3 | Blank | −2.233 | 0.306 | −0.400 | 0.346 | −0.733 | 0.404 | −3.367 | 0.252 | −0.567 | 0.153 | −0.733 | 0.153 |
| Control | 1.233 | 0.379 | −2.667 | 0.058 | −8.800 | 1.992 | 1.967 | 0.379 | −1.600 | 0.100 | −4.867 | 1.629 | |
| THK−30 | 3.133 | 0.611 | −2.400 | 0.000 | −3.600 | 1.836 | 5.133 | 0.153 | −3.033 | 0.153 | −9.100 | 1.833 | |
| SHMP | 5.933 | 0.252 | −2.633 | 0.115 | −7.400 | 2.821 | 4.567 | 0.231 | −2.367 | 0.115 | −9.467 | 2.053 | |
| Mix | 4.233 | 0.058 | −3.233 | 0.058 | −8.200 | 1.836 | 5.167 | 0.153 | −2.500 | 0.265 | −7.267 | 3.202 | |
| 4 | Blank | −2.200 | 0.624 | −1.100 | 0.265 | −2.533 | 0.503 | −0.533 | 0.493 | −0.067 | 0.321 | −1.600 | 1.735 |
| Control | 3.067 | 0.493 | −1.633 | 0.153 | −6.467 | 2.857 | 2.900 | 0.400 | −0.633 | 0.115 | −0.800 | 1.442 | |
| THK−30 | 3.767 | 0.058 | −2.933 | 0.153 | −8.600 | 1.873 | 5.767 | 0.577 | −2.233 | 0.115 | −8.867 | 2.026 | |
| SHMP | 5.233 | 0.115 | −3.067 | 0.058 | −9.433 | 1.484 | 5.833 | 0.404 | −2.067 | 0.153 | −7.933 | 1.747 | |
| Mix | 6.000 | 0.361 | −2.933 | 0.058 | −8.133 | 1.677 | 5.300 | 0.529 | −2.900 | 0.300 | −9.367 | 2.122 | |
Disclaimer/Publisher’s Note: The statements, opinions and data contained in all publications are solely those of the individual author(s) and contributor(s) and not of MDPI and/or the editor(s). MDPI and/or the editor(s) disclaim responsibility for any injury to people or property resulting from any ideas, methods, instructions or products referred to in the content. |
© 2024 by the authors. Licensee MDPI, Basel, Switzerland. This article is an open access article distributed under the terms and conditions of the Creative Commons Attribution (CC BY) license (https://creativecommons.org/licenses/by/4.0/).
Share and Cite
Nguyen, T.T.M.; Zheng, Q.; Yi, E.-J.; Bellere, A.D.; Jin, X.; Kim, H.-Y.; Yi, T.-H. The Potential Teeth Bleaching and Halitosis Prevention Effects of Pediococcus inopinatus THK-30, a Kimchi-Derived Lactic Acid Bacterium: In Vitro Study. J. Funct. Biomater. 2024, 15, 64. https://doi.org/10.3390/jfb15030064
Nguyen TTM, Zheng Q, Yi E-J, Bellere AD, Jin X, Kim H-Y, Yi T-H. The Potential Teeth Bleaching and Halitosis Prevention Effects of Pediococcus inopinatus THK-30, a Kimchi-Derived Lactic Acid Bacterium: In Vitro Study. Journal of Functional Biomaterials. 2024; 15(3):64. https://doi.org/10.3390/jfb15030064
Chicago/Turabian StyleNguyen, Trang Thi Minh, Qiwen Zheng, Eun-Ji Yi, Arce Defeo Bellere, Xiangji Jin, Hong-Yong Kim, and Tae-Hoo Yi. 2024. "The Potential Teeth Bleaching and Halitosis Prevention Effects of Pediococcus inopinatus THK-30, a Kimchi-Derived Lactic Acid Bacterium: In Vitro Study" Journal of Functional Biomaterials 15, no. 3: 64. https://doi.org/10.3390/jfb15030064










